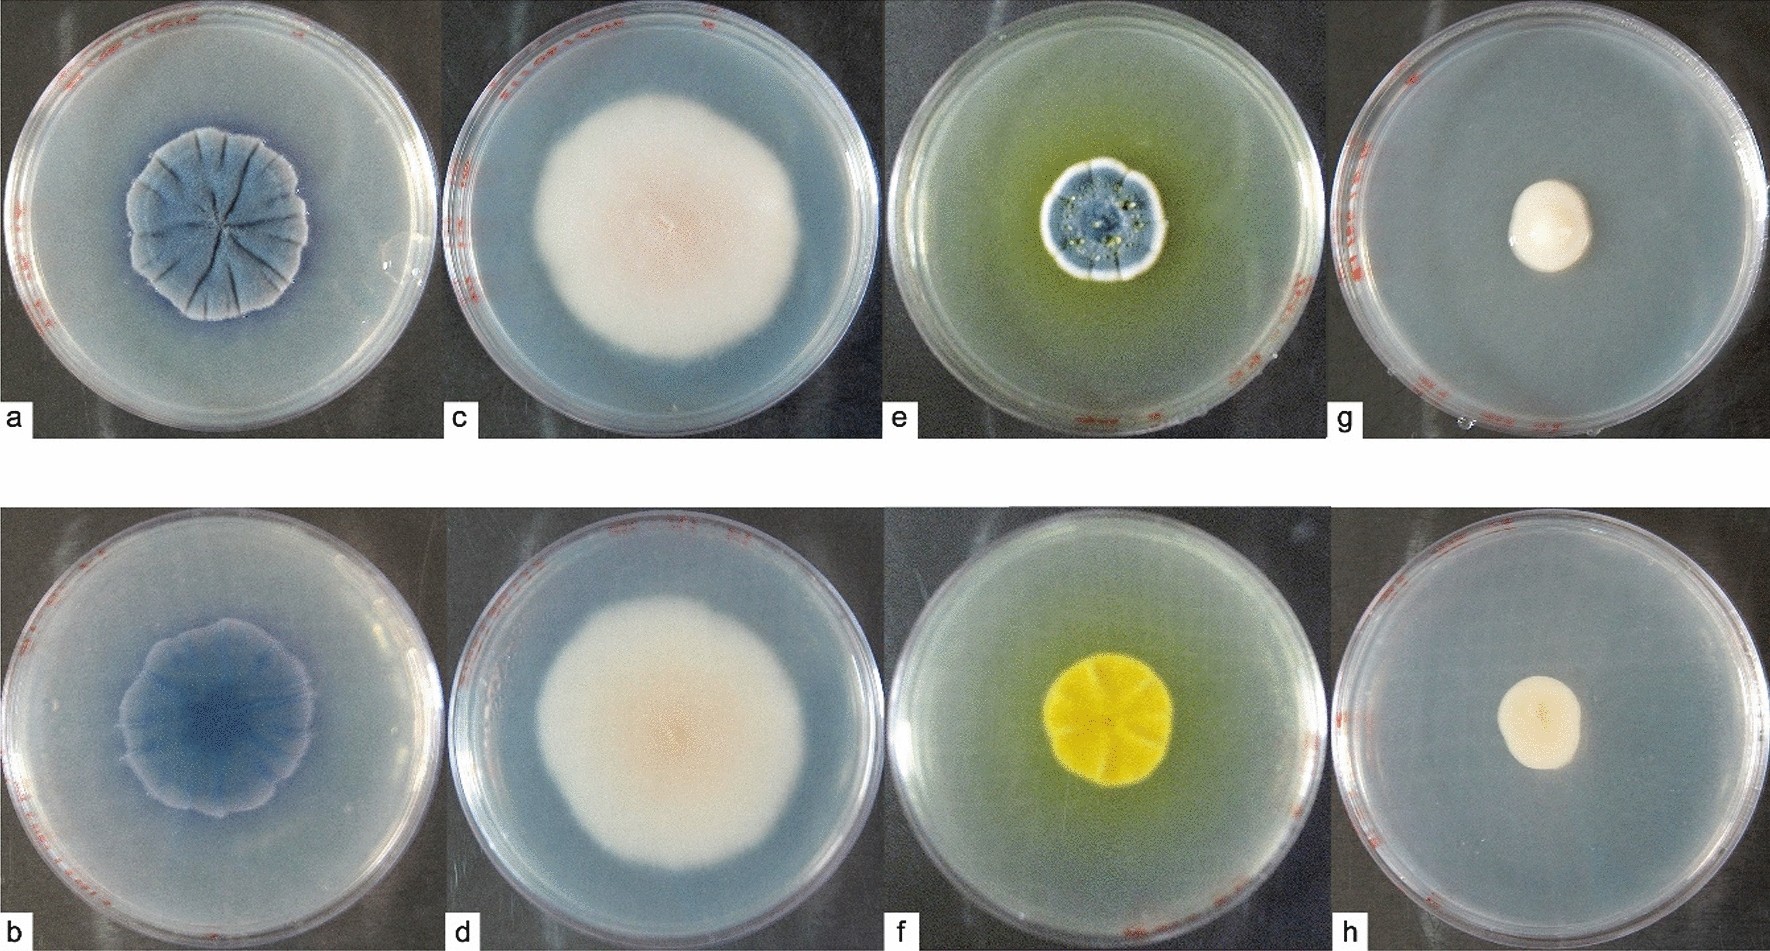
Figure 2

Figure 2
From: Antarctic fungi with antibiotic potential isolated from Fort William Point, Antarctica
Macroscopic observation of Antarctic fungi isolates. Colonies were grown on PDA for 30 days at 4 °C. Upper panel: front of the colony. Lower panel: reverse of the colony. (a,b) Antarctomyces sp.; (c,d) Thelebolus sp.; (e,f) Penicillium sp.; (g,h) Cryptococcus gilvescens.